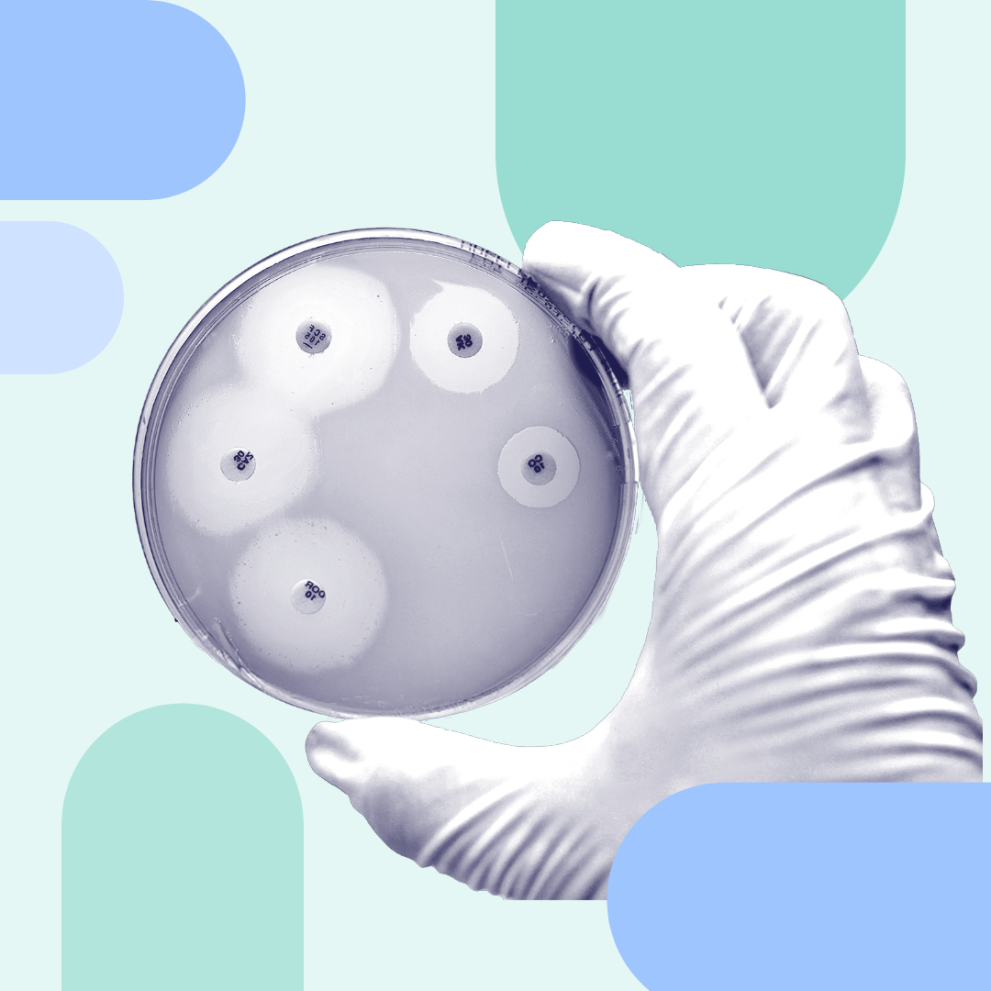
Gloved hand holding a Petri dish to symbolise work done to develop antimicrobial medicines

Antimicrobial resistance
Combatting the threat of antimicrobial resistance is a high priority for the European Medicines Agency (EMA) and the European medicines regulatory network.
HumanVeterinaryAntimicrobial resistance
The emerging and steady increase of microbes that are resistant to antimicrobial treatments has become a global public health threat. This is due to a lack of therapeutic options to treat certain infections in humans.
Antimicrobial resistance threatens the effective treatment of infectious diseases. It happens when a microbe evolves to become more or fully resistant to antimicrobials which previously could treat it.
Antimicrobials include antibiotics, which kill or inhibit the growth of bacteria.
Meticillin-resistant Staphylococcus aureus (MRSA) is a well-known example of a bacterium that is resistant to a number of antibiotics. This bacterium has caused infections that are difficult to treat across the European Union (EU).
Although the development of resistance occurs naturally when microorganisms replicate themselves erroneously or when resistant traits are exchanged between them, the use and misuse of antimicrobials accelerates the emergence of resistant strains.
The lack of new antibiotics entering the market exacerbates the problem.
Antimicrobial resistance affects both humans and animals. Resistance can also spread from animals to humans through the food chain or direct contact.
For information, see:
Without action, annual deaths caused by antimicrobial resistance could escalate to 390,000 by 2050.
Novel antimicrobial medicines and alternatives as well as quick diagnostics are required.
This corresponds to less than 4% of the total number of marketing authorisation recommendations that EMA made in the same period.
For more information, see:
EMA plays a vital role in the global response to the threat of antimicrobial resistance, by:
EMA supports a 'One Health' approach, promoting a close and integrated cooperation between the human and veterinary fields. For more information on our work in each sector, see:
Every year, European Antibiotic Awareness Day (EAAD) takes place on 18 November.
The Day is a health initiative that provides a platform and support for national campaigns on the prudent use of antibiotics in the EU / European Economic Area (EEA). The European Centre for Disease Prevention and Control (ECDC) coordinates this initiative.
In 2025, EMA launched its podcast series 'Inside EMA'. This podcast introduces you to the scientists, regulators and experts working to ensure that medicines for people and animals in the EU are safe, effective and of high quality. The first episode focused on addressing antimicrobial resistance.
For more information on EMA's podcast, see:
Antimicrobial resistance (AMR) is a growing silent pandemic that demands immediate and decisive action.
EMA is ready to engage in early dialogue with and support pharmaceutical companies, academia, and small and medium-sized enterprises (SMEs) to facilitate medicine development.
We do this through our Emergency Task Force (ETF), which can help develop new medicines to address the AMR public health crisis.
See EMA infosheet on antimicrobial resistance
Between 2019 and 2023, antibiotic consumption in the EU increased by 1%, according to the ECDC.
This moves the EU further away from the 2030 target of reducing antibiotic consumption by 20%, as the Council of the European Union recommends.
The ECDC is calling for accelerated efforts in three main areas: infection prevention and control, prudent use of antimicrobials, and the development of and access to novel antimicrobials.
In 2021, an European Commission Eurobarometer survey on the use and perceptions of antibiotics in the EU highlighted that Europeans still take antibiotics without justification. This includes taking them:
For more information, see:
EMA, the European Centre for Disease Prevention and Control (ECDC), European Food Safety Authority (EFSA) and European Environment Agency (EEA) published a factsheet on how the EU agencies support the fight against antibiotic resistance and help to ensure that antibiotics remain effective.
The four EU agencies, joined by the European Chemicals Agency (ECHA), are also collaborating in the One Health framework.
This aims to mitigate the impact and societal cost of health threats while helping to reduce human pressures on the environment and safeguarding key societal needs such as food security and access to clean air and water.
For more information, see:
EMA supports the European Commission's 'One Health' action plan against antimicrobial resistance.
In 2017, the European Commission published EU guidelines on the prudent use of antimicrobials in human health.
This followed the guidelines on prudent use of antimicrobials in veterinary medicine published in 2015.
EMA also supported the European Commission's previous action plan against the rising threats from antimicrobial resistance. It did so by providing scientific input and recommendations on the use of antibiotics in animals. This was in partnership with other relevant EU bodies, including the European Centre for Disease Prevention and Control (ECDC) and the European Food Safety Authority (EFSA).
For more information, see:
Select the expandable panels below to learn about EMA's involvement in global initiatives alongside its international partners:
EMA, the Japanese Pharmaceuticals and Medical Devices Agency (PMDA) and the United States' Food and Drug Administration (FDA) are working together to facilitate a single development program for new antibacterials that satisfies the regulatory requirements of each of the three agencies.
At a third meeting between the three agencies in October 2017, they agreed to align how clinical trials should be designed to study the effects of new antibiotics in certain indications. These include uncomplicated gonorrhoea or uncomplicated urinary tract infections.
They also committed to working together to explore how to better streamline paediatric development of new antibacterial agents. For more information, see:
At their second meeting in April 2017, the agencies agreed to align their data requirements for certain aspects of the clinical development of new antibiotics. This is in order to stimulate the development of new treatments. For more information, see:
The agencies first met in September 2016 to discuss regulatory approaches for the evaluation of antibacterial agents.
They concluded that a comprehensive and multifaceted response is needed to encourage and accelerate development of new antibacterial medicines. They also agreed to explore common regulatory approaches. For more information, see:
The EU and the United States (US) established the Transatlantic Task Force on Antimicrobial Resistance (TATFAR). This was a result of the 2009 US-EU summit to intensify cooperation in the fight against antimicrobial resistance.
By 2021, government agencies from Canada, Norway, and the United Kingdom also joined. EMA is a member of TATFAR.
The taskforce aims to increase levels of communication, coordination and cooperation between the EU and the US on human and veterinary antimicrobials.
For more information on TATFAR's activities, see: